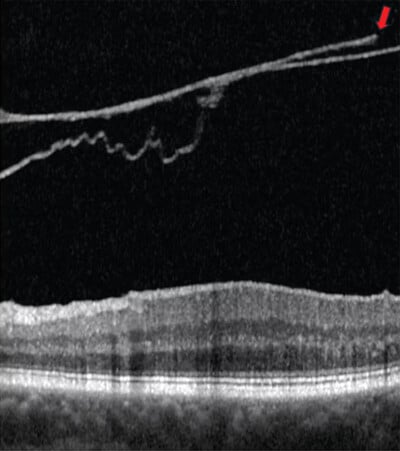

You are currently on the International (English) version.
Looks like you are in United States.
Switch to local content?
The article by Jim Williamson, OD, explores the anatomy and function of this lesser-known body and how SPECTRALIS OCT helps monitor for disease or injury.

Are you vitreous-curious? In his article in Optometry Times, Jim Williamson, OD, delves into the anatomy of this lesser understood body, its function within the eye, and the power of SPECTRALIS OCT imaging to enable eyecare providers to properly monitor for signs of disease or injury.
A break in the posterior vitreous cortex appears (arrow)
Image courtesy: Jim Williamson, OD